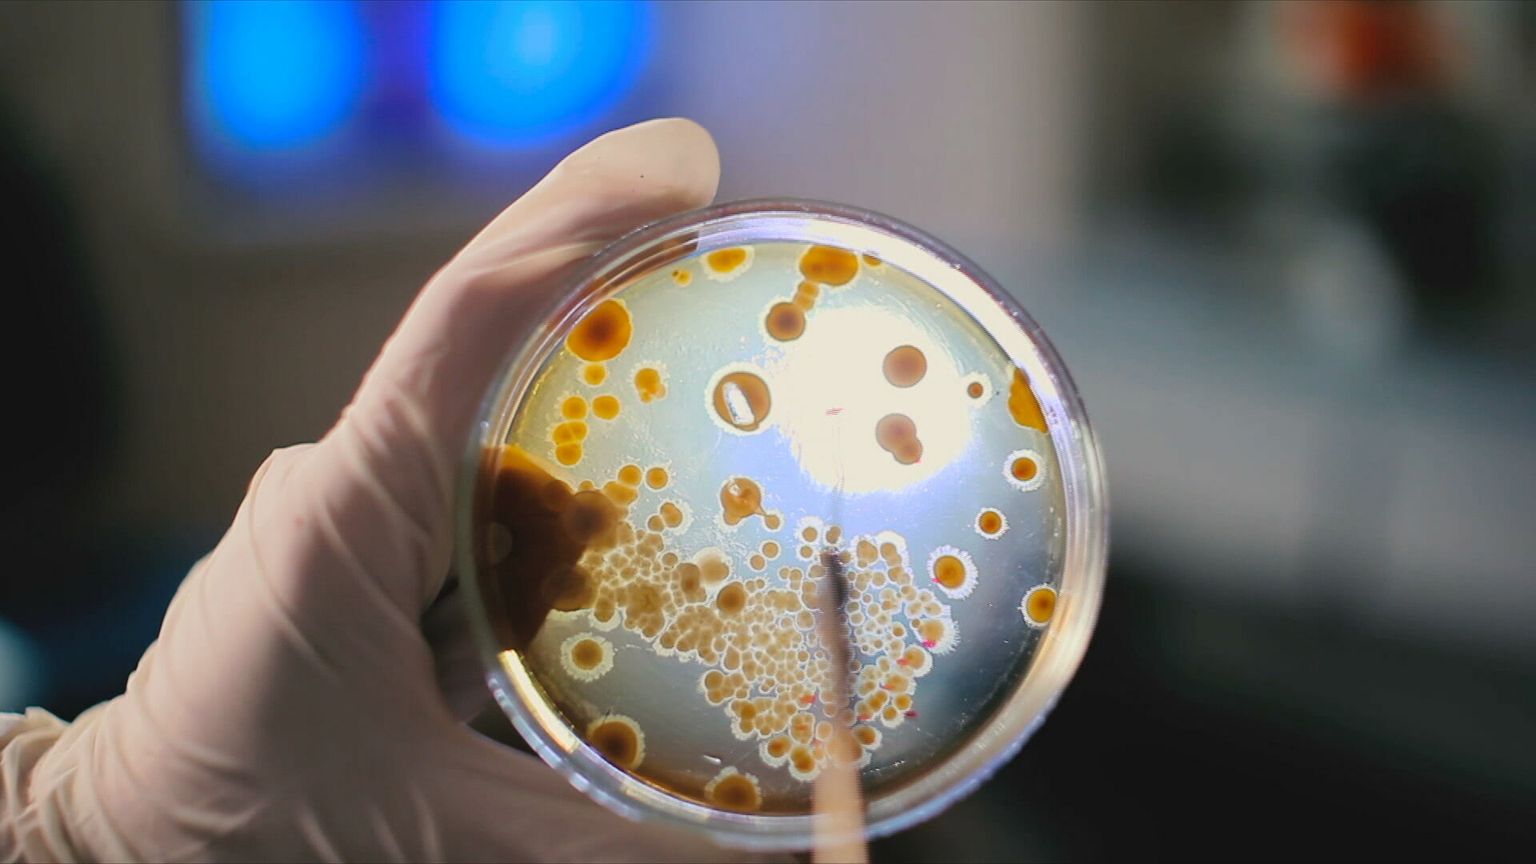

-
 Antraks - 5 Foto: DNEVNIK.hr
Antraks - 5 Foto: DNEVNIK.hr -
 Antraks - 4 Foto: DNEVNIK.hr
Antraks - 4 Foto: DNEVNIK.hr -
 Antraks - 2 Foto: DNEVNIK.hr
Antraks - 2 Foto: DNEVNIK.hr -
 Antraks - 3 Foto: DNEVNIK.hr
Antraks - 3 Foto: DNEVNIK.hr -
Antraks - 1 Foto: DNEVNIK.hr
Antraks - 1 Foto: DNEVNIK.hr -
Pogledaj i ovo





Zaraza
Što je bedrenica, bolest koja je izazvala velik pomor stoke? Kod ljudi se pojavljuju tri oblika bolesti, ovo su simptomi





izdane preporuke
Sve više oboljelih od COVID-a, epidemiolog otkrio kakvi su simptomi: "Ovi se mogu pojaviti kod djece..."





uzbuna u slavoniji
Potvrđeni novi slučajevi smrtonosnog virusa, ministar: "Izvanredno stanje će prestati tek kad..."

